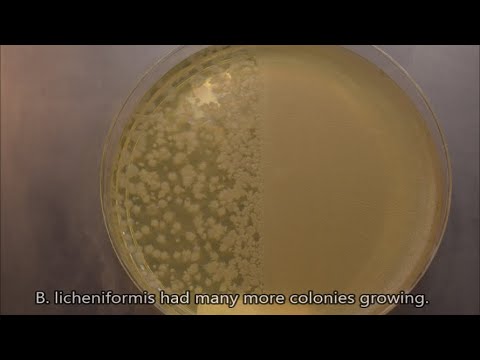

Sped-up microscopic video of yeast cells producing carbon dioxide bubbles through the process of fermentation. Camera - Nikon D3300 Microscope - Leica ATC 2000 Microscope magnification of each shot is shown in the bottom right hand corner. Music by Sci-inspi Apple music: Spotify: Donate to support my channel: